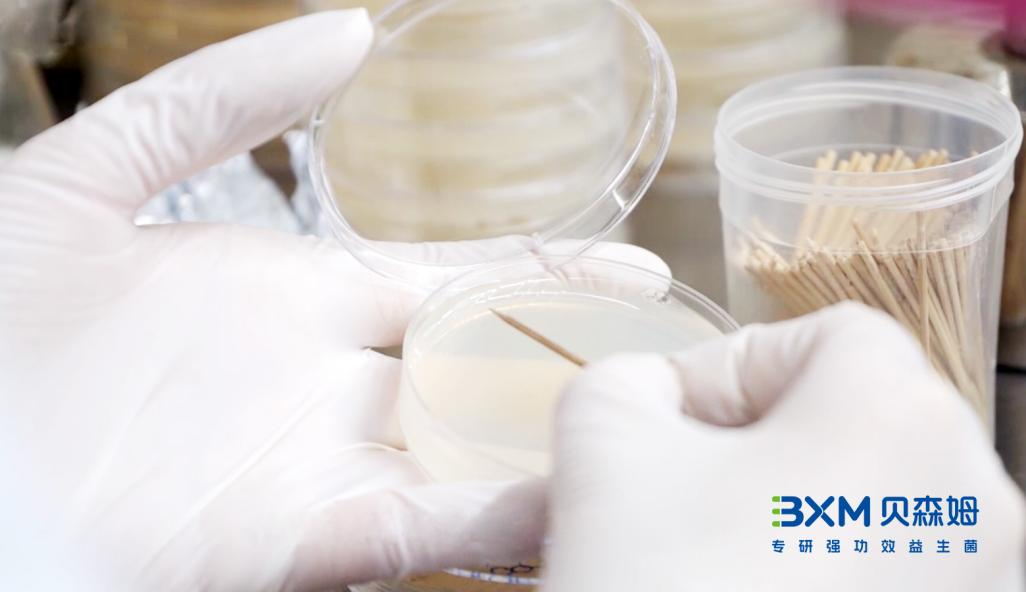
图片3.png

随着健康意识的不断提升,益生菌因其对人体健康的潜在益处而备受关注。然而,在益生菌领域中,两个关键术语——菌种(species)和菌株(strain)常常被混淆。尽管它们看似相近,但在微生物学和临床应用中有着显著的区别。作为专研强功效益生菌的生产企业,元之道致力于为消费者提供科学严谨的产品。本文将深入探讨菌种和菌株的区别,揭示益生菌科学的核心。

▲菌群、菌属、菌种、菌株的关系图
菌种:微生物分类的基本单位
菌种是微生物分类学中的一个基本单位,类似于动植物分类中的“种”。在系统发生学上,菌种是指一群具有相似遗传和生理特征的微生物个体。每一个菌种都有其独特的形态、生理特性和生态位。例如,乳酸杆菌(Lactobacillus)和双歧杆菌(Bifidobacterium)是常见的益生菌种,它们在发酵乳糖、生成乳酸、抑制有害菌生长等方面表现出不同的功能。
菌株:菌种内部的特定个体
菌株是从菌种中分离出来的具有独特遗传特性和生理功能的个体。可以将菌株看作是菌种的“子集”或“变种”。即使同属于一个菌种,不同的菌株在功能和效果上可能有显著差异。例如,Lactobacillus rhamnosus GG(LGG)和Lactobacillus rhamnosus GR-1虽然同属于乳酸杆菌属,但在促进肠道健康和免疫调节方面展现出不同的临床效果。

▲元之道强功效实验室的菌株资源库一角
菌种与菌株的关系
菌种与菌株的关系类似于树与树叶的关系。菌种是一个更大的分类单位,包含多个菌株。每个菌株都有其独特的基因序列和功能特性。理解菌种和菌株的区别对于科学研究和产品开发至关重要,因为不同的菌株在临床研究中可能表现出不同的效果和安全性。
菌株选择的重要性
在益生菌产品的研发和应用中,菌株的选择至关重要。以下是几个关键原因:
①特定功效:某些菌株在临床试验中被证明具有特定的健康功效。例如,LGG菌株在改善肠道健康、增强免疫力和预防腹泻方面有广泛的研究支持。
②安全性:不同菌株的安全性可能不同。经过严格筛选和研究的菌株更有保障。例如,某些菌株可能在特定人群中引发不良反应,而其他菌株则被证明在广泛人群中是安全的。
③稳定性:某些菌株在生产、储存和运输过程中更为稳定,能够更好地保持活性。这对于确保益生菌产品的有效性至关重要。
▲元之道研发人员进行菌种筛选画面
元之道的科研优势
作为一家专研强功效益生菌的生产企业,元之道深知菌株选择的重要性。我们通过严格的科学研究和临床试验,筛选和培养最具潜力的益生菌株。我们的科研团队致力于揭示每个菌株的独特特性和功能,确保产品在安全性、稳定性和功效性方面达到最高标准。
为了确保益生菌产品的有效性和安全性,元之道积极参与和支持多项临床研究。这些研究不仅验证了特定菌株的健康功效,还帮助我们了解其在不同人群中的应用潜力。例如,元之道专利明星菌株——BXM2菌株在缓解肠易激综合征(IBS)症状方面具有显著效果,而其他菌株则在增强免疫功能、防治感染性腹泻等方面表现突出。

▲元之道研发人员观察菌株情况
知识点:
BXM2是在中国发现的神奇菌株,我们经过大量的研究工作发现BXM2对中国人的肠道环境具有非常高的健康价值,具有高活性、强功效、高抗逆、高定植的特性。
菌种和菌株虽然只有一字之差,却代表了益生菌研究和应用中的两个不同层次。菌种是益生菌的基本分类单位,而菌株则是从菌种中筛选出来的具有特定功能的个体。了解它们的区别,有助于我们更科学地选择和使用益生菌产品。元之道自创立以来,始终坚定与人类社会健康可持续发展保持同频坚持将客户的需求放在经营首位,通过不断研发新的强功效菌株和配方,致力于将“更具竞争力”的益生菌产品推向市场。我们会倾听您的需求,运用我们丰富的研发经验及专业市场洞察能力,随时为您提供明星畅销产品解决方案。